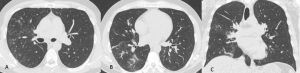
image

- Poster No.
- PD-10/55
- Tipo
- E-POSTER DIDATTICO
- Sezione
- Radiologia Toracica
- Autori
- Michela SCUTTI - CHIETI (CH), Daniele VERI , Marco MASTANDREA , Manuela MEREU , Rosa Lucia PATEA , Massimo CAULO
Obiettivi didattici:
Introduzione:
Numerose sono le cause di insufficienza respiratoria acuta (IRA), tra quelle più comuni ricordiamo l’edema polmonare e le polmoniti, meno frequente ma comunque grave è l’emorragia alveolare. Tali patologie coinvolgono frequentemente l’alveolo determinando la riduzione o la sostituzione del normale contenuto aereo con conseguente incremento dell’attenuazione dei raggi X rispetto al parenchima polmonare circostante determinando in TCAR la formazione del pattern di aumentata densità.
Il pattern di aumentata densità può essere a “vetro smerigliato” o consolidativo.
In base al glossario della Fleischner Society si definisce “vetro smerigliato” un’area di tenue aumento della densità del parenchima polmonare nel cui contesto sono riconoscibili i margini delle strutture bronchiali e vascolari; si definisce consolidazione un’area di aumentata densità nel cui contesto non sono riconoscibili né i margini delle strutture vascolari né le pareti dei bronchi.
Il numero di pazienti che giunge al Pronto Soccorso (PS) con un quadro di IRA è aumentato nel recente periodo di pandemia.
I pazienti con febbre e IRA di cui si sospetta l’eziologia virale da SARS-CoV-2, sono temporaneamente accolti in aree dedicate ed è importante identificare subito la reale causa di IRA in modo da indirizzare il paziente verso il giusto percorso clinico-terapeutico.
La TCAR è ormai un esame fondamentale se non il principale nel sospetto di COVID-19. L’identificazione del “vetro smerigliato” e della causa ad esso sottostante è un supporto importantissimo alle attività di PS.
Di seguito si illustrano le principali patologie che causano una compromissione acuta della funzionalità respiratoria e si manifestano in TCAR con aree di iperdensità parenchimale.
Descrizione:
COVID-19
POLMONITE DA PNEUMOCYSTIS JIROVECII
- POLMONITE ORGANIZZATIVA.
- POLMONITE INTERSTIZIALE NON SPECIFICA (NSIP).
- POLMONITE DA IPESENSIBILITÀ (PI).
- POLMONITE INTERSTIZIALE ACUTA.
- EMORRAGIA DIFFUSA.
Conclusioni:
La polmonite interstiziale da SARS-CoV-2 non è l’unica patologia a manifestarsi con “vetro smerigliato” diffuso ed IRA. È importante che il radiologo sappia riconoscere i diversi quadri TCAR al fine di aiutare i clinici nella scelta del miglior iter diagnostico e terapeutico.
Informazioni Personali:
Note Bibliografiche:
- Parekh M, Donuru A, Balasubramanya R, Kapur S. Review of the Chest CT Differential Diagnosis of Ground-Glass Opacities in the COVID Era. 2020 Dec;297(3):E289-E302. doi: 10.1148/radiol.2020202504. Epub 2020 Jul 7. PMID: 32633678; PMCID: PMC7350036.
- Cozzi D, Cavigli E, Moroni C, et al. Ground-glass opacity (GGO): a review of the differential diagnosis in the era of COVID-19. Jpn J Radiol. 2021;39(8):721-732. doi:10.1007/s11604-021-01120-w
- Guarnera A, Podda P, Santini E, Paolantonio P, Laghi A. Differential diagnoses of COVID-19 pneumonia: the current challenge for the radiologist-a pictorial essay. Insights Imaging. 2021;12(1):34. Published 2021 Mar 11. doi:10.1186/s13244-021-00967-x
- Akira M, Kozuka T, Yamamoto S, Sakatami M. Computed tomography findings in acute exacerbation of idiopathic pulmonary fibrosis. Am J Respir Crit Care Med 2008; 178:372-378.doi: 10.1164/rccm.200709-1365OC.

Figura 1: Uomo di 75 anni con infezione da SARS-CoV-2. Le immagini TC assiali (A-B-C-D) e ricostruzioni MPR sul piano sagittale (E) e coronale (F) mostrano la tipica presentazione della polmonite da COVID-19 caratterizzata dalla presenza di aree di aumentata densità con aspetto a “vetro smerigliato” cui si associa ispessimento liscio dei setti interlobulari che mostrano prevalente distribuzione subpleurica. La localizzazione delle aree di iperdensità in sede subpleurica è caratteristica di questa infezione come evidenziato particolarmente nell’immagine A in cui le aree a “vetro smerigliato” si dispongono lungo la scissura del lobo accessorio dell’azygos e nell’immagine E in cui è evidente la distribuzione delle alterazioni lungo le scissure.
Figura 2: Uomo di 41 anni con infezione da virus dell’Influenza A, giunge al Pronto Soccorso con febbre, tosse, malessere e lieve dispnea. La TCAR eseguita all’ingresso mostra nelle scansioni assiali (A-B) e nella ricostruzione MPR coronale (C) la presenza di sfumati micronoduli centrolobulari nel lobo superiore destro e nel lobo medio e di aree di aumentata densità con aspetto in parte a "vetro smerigliato" ed in parte consolidativo nel lobo inferiore destro.

Figura 3: Uomo di 65 immunocompromesso affetto da polmonite da Citomegalovirus. Le immagini TCAR assiali (A-B-C) e la ricostruzione MPR coronale (D) mostrano il tipico pattern caratterizzato dalle presenza di "vetro smerigliato" diffuso in entrambi i polmoni con distribuzione simmetrica, si associa la presenza di alcune aree di aumentata densità con aspetto consolidativo in entrambi i lobi inferiori.

Figura 4: Donna di 78 anni con diagnosi di Linfoma di Hodgkin. Le immagini assiali (A-B-C) mostrano il parenchima polmonare normale. Un anno dopo la paziente giunge al Pronto Soccorso per un rapido peggioramento della funzionalità respiratoria, dispnea e tosse. La TCAR eseguita alcuni giorni dopo il ricovero nel reparto di Malattie Infettive (D-E-F) mostra la presenza in entrambi i polmoni di "vetro smerigliato" diffuso con relativo risparmio delle zone sub-pleuriche e la comparsa di formazioni pseudocistiche nel lobo superiore sinistro (frecce in D ed E). L’ipotesi formulata e poi confermata dal laboratorio è stata quella di polmonite da Pneumocystis Jirovecii.

Figura 5: Uomo di 68 anni immunocompromesso giunge al Pronto Soccorso per IRA. La TCAR eseguita all’ingresso (immagini assiali A-B-C e la ricostruzione MPR sul piano coronale D) mostrano "vetro smerigliato" diffuso e simmetrico in entrambi i polmoni con relativo risparmio delle aree sub-pleuriche solo in alcune zone nel polmone. L’ipotesi diagnostica formulata è stata quella di polmonite interstiziale. Le indagini di laboratorio hanno in seguito rivelato che l’agente patogeno responsabile del quadro flogistico era lo Pneumocystis Jirovecii. La diagnosi differenziale tra le varie cause di iperdensità parenchimale nei pazienti con IRA non è semplice soprattutto quando le alterazioni sono molto estese e diffuse.

Figura 6: Donna di 73 anni giunge in Pronto Soccorso per febbre, dispnea e dolore addominale. La TCAR eseguita due giorni dopo il ricovero (immagini assiali A-B-C e ricostruzione MPR sul piano coronale D), mostra la presenza nel lobo superiore sinistro di un’area di aumentata densità con aspetto prevalentemente consolidativo ed in parte a "vetro smerigliato" con broncogramma aereo nel contesto, reperti tipici di polmonite batterica. Il BAL eseguito in seguito conferma l’ipotesi di polmonite batterica, l’agente eziologico isolato è la Legionella.

Figura 7: Uomo di 67 anni ricoverato per polmonite batterica confermata anche dalla radiografia del torace eseguita all’ingresso in Pronto Soccorso. In considerazione dell’aggravarsi del quadro clinico viene richiesto un approfondimento diagnostico tramite TCAR (immagini assiali A-B ed MPR coronale C ed MPR sagittale D), da cui si evidenzia la presenza nel lobo inferiore dx di un area di aumentata densità con aspetto consolidativo nel cui contesto si osservano multiple aree a densità aerea, reperti compatibili con ascesso polmonare, possibile complicazione della polmonite batterica.

Figura 8: Donna di 62 anni con infezione da botulino e polmonite ab-ingestis. La TCAR eseguita all’ingresso al Pronto Soccorso (MPR coronale A e immagini assiali B e C) mostra la presenza di aree di aumentata densità con aspetto in parte consolidativo ed in parte a "vetro smerigliato" in entrambi i lobi inferiori e nella lingula con la presenza di stria atelettasica nella lingula.

Figura 9: Uomo di 65 anni giunto al Pronto Soccorso dopo aver rischiato la morte per annegamento. La TCAR eseguita all’ingresso (immagini assiali A-B-C e ricostruzione MPR coronale D) mostra la presenza di aree di aumentata densità con aspetto a "vetro smerigliato" in entrambi i polmoni con associato ispessimento liscio dei setti interlobulari con tipica distribuzione gravitazionale.

Figura 10: Donna di 53 anni bracciante agricola, giunge al Pronto Soccorso per febbre, dispnea ingravescente, tosse e mialgia. La TCAR eseguita all’ingresso (A e B) mostra "vetro smerigliato" diffuso cui si associano aree di ipodensità parenchimale e aree di parenchima normale in rapporto a "three density" pattern. Le scansioni effettuate in espirazione (C e D) mostrano inoltre la presenza di aree di intrappolamento aereo. L’ipotesi diagnostica formulata (in seguito confermata) in considerazione dei reperti TC e dell’anamnesi lavorativa della paziente è stata quella di polmonite da ipersensibilità in fase acuta/subacuta non fibrosante.

Figura 11: Uomo di 68 anni giunge in Pronto Soccorso per grave dispnea, IRA e febbre, esegue TC TORACE all’ingresso nel sospetto di polmonite da SARS-CoV-2. La TCAR (scansioni assiali A-B-C-D) documenta ispessimento liscio dei setti interlobulari in entrambi i polmoni più evidente in sede perilare e nei lobi inferiori ove si associa la presenza di alcune aree di aumentata densità con aspetto a "vetro smerigliato" maggiori a destra. Si associa falda di versamento pleurico bilaterale. L’ipotesi diagnostica formulata ed in seguito clinicamente confermata è stata quella di alterazioni di natura emodinamica.

Figura 12: Donna di 70 anni affetta da tumore al polmone in trattamento con un inibitore della tirosin-chinasi. Trascorsi 15 giorni dall’inizio della terapia la paziente lamenta sempre maggiori difficoltà respiratorie e tosse. Alla TC di controllo (scansioni assiali A-B-C-D) si rileva "vetro smerigliato" diffuso in entrambi i polmoni ed ispessimento liscio di alcuni setti interlobulari. Si giunge alla diagnosi di pneumpatia indotta da farmaci dopo aver escluso le ipotesi di edema cardiogeno e di infezione polmonare.

Figura 13: Uomo di 45 anni giunge in Pronto Soccorso per IRA e grave anemizzazione. La TCAR eseguita all’ingresso (scansioni assiali A-B-C e ricostruzione MPR sul piano coronale D) mostra la presenza in entrambi i polmoni di multiple aree di aumentata densità con aspetto in parte a "vetro smerigliato" ed in parte consolidativo con broncogramma aereo nel contesto e distribuzione simmetrica, prevalente in sede perilare con risparmio delle zone subpleuriche. In considerazione della clinica e della distribuzione delle lesioni l’ipotesi diagnostica formulata (in seguito confermata dal BAL) è quella di emorragia alveolare diffusa.

Figura 14: Paziente di sesso femminile, 75 anni, con storia di interstiziopatia polmonare inquadrata come UIP probabile dal 2018. La paziente giunge al Pronto Soccorso per repentino e grave peggioramento della funzionalità respiratoria. Le immagini TCAR assiali (A-B) documentano la presenza in entrambi i polmoni di multiple aree a “vetro smerigliato” con distribuzione diffusa. Dopo aver escluso le ipotesi di edema cardiogeno e di infezione polmonare viene posta diagnosi di esacerbazione di fibrosi polmonare idiopatica.